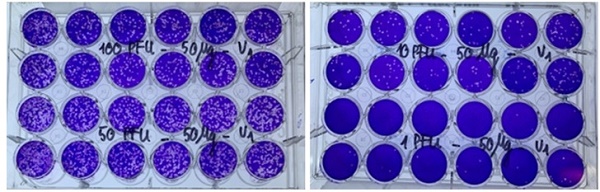

Ngay khi dịch COVID-19 bùng phát, PGS.TS.NCVCC. Lê Quang Huấn và cộng sự tại Viện Công nghệ sinh học thuộc Viện Hàn lâm Khoa học và Công nghệ đã bắt tay nghiên cứu thuốc ức chế virus SARS-CoV-2 từ thảo dược. Đến nay, nhóm đã tạo ra một chế phẩm thuốc y học cổ truyền thực sự có triển vọng trong điều trị bệnh COVID-19.
Kết quả nghiên cứu tiền lâm sàng cho thấy, sản phẩm an toàn và có tác dụng ức chế sự phát triển của virus SARS-CoV-2, tăng cường miễn dịch trên các mô hình nghiên cứu thực nghiệm.
PGS.TS Chu Hoàng Hà, Phó Chủ tịch Việt Hàn lâm Khoa học và Công nghệ Việt Nam cho biết: “Đây là thuốc điều trị COVID-19 từ dược liệu Việt Nam đầu tiên được cho phép thử nghiệm lâm sàng tại nước ta”.
TS. Nguyễn Ngô Quang, Phó Cục trưởng Cục Khoa học công nghệ và đào tạo (Bộ Y tế) đánh giá đây là một trong những minh chứng sinh động về việc các bộ, ngành, trong đó có Viện Hàn lâm Khoa học và Công nghệ Việt Nam, thực hiện chỉ đạo của Đảng, Chính phủ và đặc biệt là Thủ tướng Chính phủ trong việc ưu tiên mọi nguồn lực để phục vụ công tác phòng, chống dịch.
Tuy nhiên, theo quy định, thuốc VIPDERVIR cần tiếp tục được nghiên cứu, thử nghiệm lâm sàng để có thể đánh giá hiệu quả điều trị COVID-19 trước khi sử dụng đại trà.
Ông Nguyễn Ngô Quang cho biết, ngày 7/8, Hội đồng Đạo đức trong nghiên cứu y sinh học quốc gia (Bộ Y tế) đã đánh giá cao kết quả nghiên cứu tiền lâm sàng và chấp thuận đề cương nghiên cứu lâm sàng trên bệnh nhân COVID-19 với thuốc VIPDERVIR.
“Việt Nam hiện nay đang rất cần loại thuốc điều trị COVID-19 có nguồn gốc từ dược liệu trong nước như VIPDERVIR để phục vụ điều trị cho bệnh nhân COVID-19 có triệu chứng nhẹ và vừa. Nếu kết quả thử nghiệm lâm sàng an toàn, hiệu quả, có thể sẽ giúp thay đổi chiến lược trong điều trị bệnh nhân COVID-19 ở Việt Nam”, ông Nguyễn Ngô Quang nói.
Vì vậy, Bộ Y tế sẽ tạo điều kiện tốt nhất cho quá trình thử nghiệm lâm sàng trên nguyên tắc khoa học nhất, khách quan nhất và nhanh nhất để có thể đưa sản phẩm ra phục vụ cho người dân.
Thuốc VIPDERVIR sẽ trải qua 3 giai đoạn thử nghiệm lâm sàng. Trong đó, giai đoạn 1, đánh giá tính an toàn, sẽ được rút ngắn do thuốc có nguồn gốc hoàn toàn từ dược liệu y học cổ truyền. Giai đoạn 2 sẽ thử nghiệm lâm sàng trên 60 bệnh nhân COVID-19 để đánh giá khả năng giảm tải lượng virus của thuốc cũng như số liều tối ưu. Giai đoạn 3 sẽ thử nghiệm trên 200 bệnh nhân của Bệnh viện Bệnh Nhiệt đới Trung ương, Bệnh viện Đa khoa Đức Giang và Bệnh viện Đa khoa Đống Đa.
“Chúng tôi sẽ tạo điều kiện tốt nhất cho toàn bộ quá trình lâm sàng. Nếu đáp ứng đủ tiêu chuẩn, tính an toàn, hiệu quả, dự kiến đến cuối năm nay, chúng ta có thể xem xét cấp phép lưu hành sản phẩm này”, ông Nguyễn Ngô Quang nói và cho biết thêm, nếu sản phẩm đáp ứng các tiêu chí an toàn, hiệu quả, đạo đức thì có thể chỉ định sử dụng ngay trong điều trị bệnh nhân thể nhẹ và vừa.
Ức chế sự phát triển của virus SARS-CoV-2
Theo chia sẻ của PGS.TS.NCVCC. Lê Quang Huấn, chủ nhiệm đề tài, nhóm nghiên cứu đã sử dụng công nghệ hiện đại tin sinh học (Docking với phần mềm AutoDock) để sàng lọc các hoạt chất chính có trong các thảo dược Việt Nam có ái lực liên kết mạnh với các đích phân tử, là các phân tử liên quan tới quá trình xâm nhập và tăng sinh của virus SARS-CoV-2, phối hợp các tài liệu y văn xưa và nay, các công bố quốc tế gần đây để tạo được tổ hợp các loại thảo dược chứa các hoạt chất đã sàng lọc nhằm tạo ra sản phẩm có hiệu quả điều trị cao nhất trên cơ sở có được sự tương tác cộng hưởng của các hoạt chất theo các cơ chế khác nhau: Ngăn cản sự bám dính của virus với tế bào chủ, làm mất khả năng xâm nhập của virus vào trong tế bào chủ; Ức chế khả năng nhân lên của virus trong tế bào (đối với những hạt virus đã xâm nhập vào bên trong tế bào chủ); Kích hoạt các tế bào miễn dịch để chúng nhận biết, phong tỏa và loại trừ các hạt virus.
Sản phẩm VIPDERVIR do nhóm nghiên cứu tạo ra đã được đánh giá độc tính cấp, độc tính bán trường diễn tại Bộ môn Dược lý thuộc Đại học Y Hà Nội, Viện Kiểm nghiệm Thuốc Trung ương; được đánh giá khả năng ức chế virus H5N1 tại Viện Công nghệ sinh học, ức chế virus SARS-CoV-2 tại Viện Vệ sinh dịch tễ Trung ương.
Kết quả nghiên cứu tiền lâm sàng đã chứng minh tính an toàn và khả năng ức chế phát triển của virus SARS-CoV-2 cũng như tác dụng tăng cường miễn dịch. Đây là cơ sở khoa học quan trọng để tiếp tục nghiên cứu hiệu quả điều trị COVID-19 trên người bệnh ở giai đoạn lâm sàng.
Không nhầm lẫn với thực phẩm bảo vệ sức khỏe
Tuy nhiên, sau khi kết quả nghiên cứu thành công giai đoạn tiền lâm sàng thuốc thử nghiệm điều trị COVID-19 có tên là VIPDERVIR được công bố, hiện nay, trên một số trang tin điện tử có ý kiến khác nhau về sản phẩm thuốc thử nghiệm VIPDERVIR và thực phẩm bảo vệ sức khoẻ VIPDERVIR-C của Công ty Cổ phần dược phẩm Vinh Gia.
Đại diện Viện Hàn lâm Khoa học và Công nghệ cho biết, ngày 12/8, Viện Công nghệ sinh học đã ban hành công văn số 421/CHSH nêu rõ việc Công ty Cổ phần dược phẩm Vinh Gia đơn phương sản xuất, đăng ký lưu hành thực phẩm bảo vệ sức khỏe VIPDERVIR-C là không đúng với nội dung hợp đồng Hợp tác công nghệ sản xuất (chế phẩm VIPDERVIR) ký ngày 20/3/2020 giữa Viện Công nghệ sinh học và Công ty Cổ phần dược phẩm Vinh Gia; yêu cầu Công ty Cổ phần dược phẩm Vinh Gia thay đổi tên thực phẩm bảo vệ sức khoẻ VIPDERVIR-C để tránh hiểu nhầm cho người tiêu dùng.
Trong bối cảnh dịch bệnh COVID-19 diễn ra rất phức tạp, Viện Hàn lâm Khoa học và Công nghệ Việt Nam đang hết sức nỗ lực tiến hành nhiều nghiên cứu, trong đó có việc nghiên cứu thử nghiệm các loại thuốc điều trị COVID-19. Từ khi bùng phát dịch COVID-19 từ đầu năm 2020 đến nay, Viện đã triển khai tích cực các nghiên cứu phục vụ phòng chống COVID-19 như: Nghiên cứu thành công bộ kit phát hiện virus SARS-CoV-2 (3/3/2020), nghiên cứu giải trình tự toàn bộ hệ gene của 4 chủng virus SARS-CoV-2 (1/6/2021) làm cơ sở thực hiện nghiên cứu vaccine và nghiên cứu các chế phẩm ức chế virus SARS-CoV-2.
Thực hiện chỉ đạo của Thủ tướng Chính phủ tại Nghị quyết số 78/NQ/CP ngày 20/07/2021, lãnh đạo Viện đã quan tâm, chỉ đạo và đẩy nhanh tiến độ các nghiên cứu đang triển khai, trong đó có công trình bào chế thuốc điều trị COVID-19 từ các thảo dược Việt Nam.
Việc nghiên cứu phát triển thuốc dựa trên nguồn thảo dược Việt Nam, kết hợp thành tích nghiên cứu y dược cổ truyền và nghiên cứu hiện đại về tin sinh học, công nghệ sinh học đã thể hiện tính chủ động, sáng tạo, quyết tâm của các nhà khoa học tại Viện Hàn lâm Khoa học và Công nghệ Việt Nam nói riêng và các nhà khoa học Việt Nam nói chung đối với nhiệm vụ phòng chống dịch bệnh COVID-19 theo chủ trương chung của Đảng và nhiệm vụ Chính phủ giao.

Về trang trước
Về trang trước Về đầu trang
Về đầu trang


















